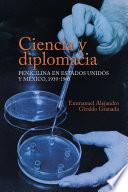

Berlín
Autor: Antony Beevor
Número de Páginas: 1751Antony Beevor reconstruye en este libro la última gran batalla europea de la segunda guerra mundial y la estremecedora agonía del Tercer Reich. Con rigurosas técnicas documentales semejantes a las empleadas en Stalingrado pero con mayor aliento épico y más densidad política, Beevor combina como nadie un extraordinario talento de militar e historiador con unas dotes narrativas fuera de lo común para describir tanto la complejidad de las grandes operaciones militares y la lógica de las decisiones de sus mandos como los sentimientos de la gente común atrapada en un torbellino de fuego y metralla: la desesperación de Hitler, los deseos de venganza de Stalin, la impotencia de Guderian o la astucia de Zhukov, pero también la paradójica inocencia de unos niños jugando a la guerra con espadas de madera en mitad de sus casas destruidas por las bombas o el asco y el resentimiento de las mujeres brutalmente violadas por soldados soviéticos al tiempo que fanáticos de las SS ejecutan a cualquiera que se atreva a ondear una bandera blanca... «Berlín se parece -ha escrito Michael Burleigh- al gran poema épico de Alexander Solzhenitsyn Noches prusianas, sólo que apoyado en...